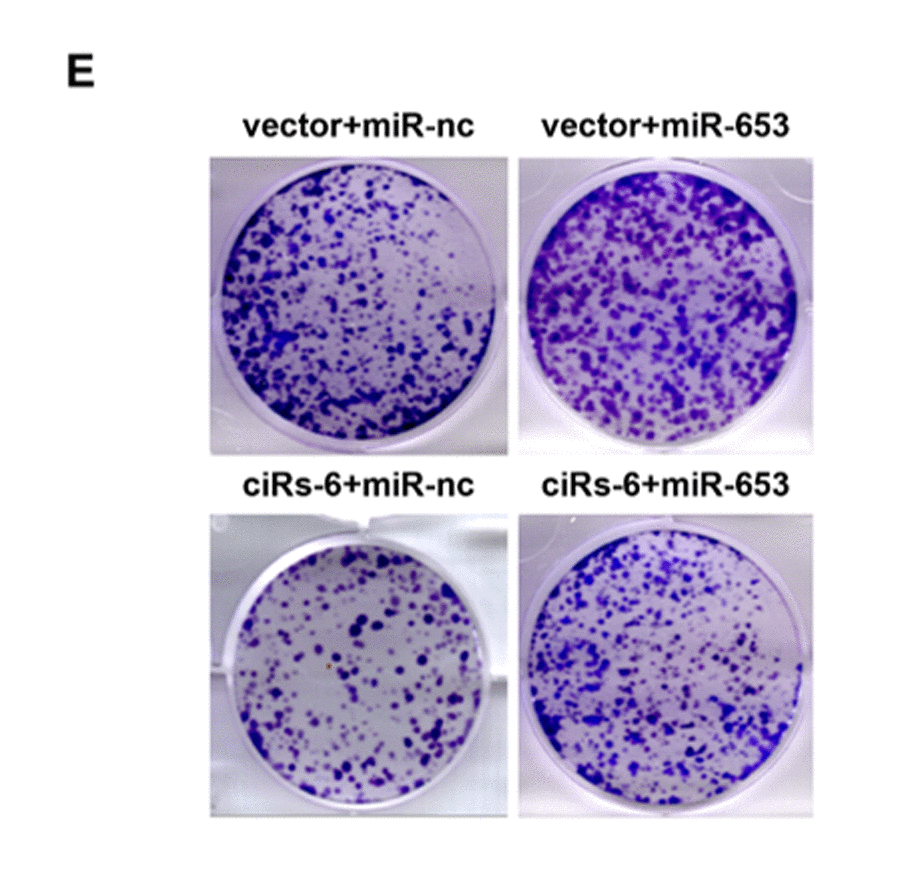

This article has been corrected: The authors requested the replacement of Figure 4E and Table 1. Figure 4E (ciRs-6+miR-nc) was quite similar to Supplementary Figure 1D (si-3 in T24 cells) and was slightly updated. Changes of Table 1 are done to correct the statistical mistakes.
These corrections do not change the content of the publication and do not affect the conclusion of this research. The authors apologize for the unintentional mistakes.
The corrected Figure and Table are provided below.
Table 1. Relationship between ciRs-6 level and clinical characteristics in bladder cancer.
| Total | Patients | Expression of ciRs-6 | |||
| High | Low | p | |||
| Age(mean) | 50 | 47.931 | 52.069 | 0.395 | |
| Gender | |||||
| Male | 45 | 22 | 23 | 0.753 | |
| Female | 13 | 7 | 6 | ||
| Tumor stage | |||||
| Tis/Ta/T1 | 31 | 22 | 9 | <0.001 | |
| T2 | 17 | 7 | 10 | ||
| T3/T4 | 10 | 0 | 10 | ||
| Grade | |||||
| High | 20 | 5 | 15 | 0.006 | |
| Low | 38 | 24 | 14 | ||
| Number of tumors | |||||
| Solitary | 41 | 23 | 18 | 0.149 | |
| Multiple | 17 | 6 | 11 | ||
| Lymph node metastasis | |||||
| Negative | 23 | 13 | 10 | 0.421 | |
| Positive | 35 | 16 | 19 | ||
| Follow-up (month, mean) | 33.23 | 33.00 | 33.45 | 0.047 | |